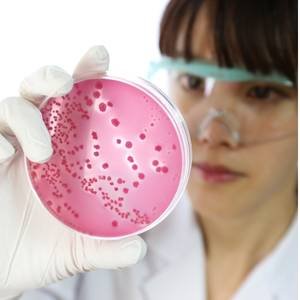
Home: Learn Microbiology 1 Basic Microbiology Quiz

Welcome to Learn Microbiology - Your Microbiology Learning Hub
LearnMicrobiology.com is your trusted platform to explore, understand, and master the fascinating world of microbiology. Whether you’re a student, educator, researcher, or just curious about microbes, our website is designed to offer easy-to-understand, in depth content tailored to all levels.
Explore well-structured and easy-to-understand microbiology notes covering key concepts, classifications, microbial physiology, genetics, immunology, and pathogenic microorganisms. Perfect for students, educators, and professionals, these notes simplify complex topics with diagrams, summaries, and exam-focused insights to help you learn faster and retain more.
What You’ll Find on Learn Microbiology
Microbiology Notes; Microbiology Practicals; Microbiology MCQs & Quizzes; Latest Research Topics in Microbiology; Top Microbiology University and Best Book for Microbiology
Select topic for Microbiology MCQs & Quizzes
Microbiology Notes 🧫
Explore well-structured and easy-to-understand microbiology notes covering key concepts, classifications, microbial physiology, genetics, immunology, and pathogenic microorganisms. Perfect for students, educators, and professionals, these notes simplify complex topics with diagrams, summaries, and exam-focused insights to help you learn faster and retain more.
Latest Research Topics In Microbiology 🧪
Stay updated with cutting-edge discoveries in the world of microbes through our Latest Research in Microbiology section. Explore recent studies, emerging trends, and innovative breakthroughs in bacteriology, virology, immunology, biotechnology, antimicrobial resistance, and microbial genomics. Perfect for students, researchers, and professionals, this section keeps you informed with concise summaries, expert insights, and references to peer-reviewed journals. Expand your knowledge and stay ahead in the fast-evolving field of microbiology.
Microbiology Interview Questions & Answers
Prepare confidently for job interviews with our curated collection of Microbiology Interview Questions and Answers. This section covers frequently asked questions from various domains, including clinical microbiology, food and industrial microbiology, pharmaceutical microbiology, and research labs. Ideal for freshers, experienced professionals, and competitive exam aspirants, our content is designed to help you understand key concepts, boost your confidence, and succeed in interviews. Stay interview-ready with expert-reviewed and industry-relevant microbiology questions.
Best Microbiology Universities
Stay updated with cutting-edge discoveries in the world of microbes through our Latest Research in Microbiology section. Explore recent studies, emerging trends, and innovative breakthroughs in bacteriology, virology, Immunology, Biotechnology, antimicrobial resistance and microbial genomics. Perfect for students, researchers, and professionals, this section keeps you informed with concise summaries, expert insights, and references to peer-reviewed journals. expand your knowledge and stay ahead in the fast-evolving field of microbiology.